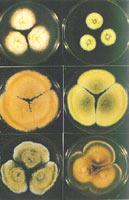

什么是霉菌?
人气:
【字体:大 中 小】
发布时间:2007-10-19 13:47:15
>>>>>>>>提问 妇科霉菌病很难治吗?为什么会的这种病啊?有了这种病应该怎么办啊?有什么好方法能更治吗?
>>>>>>>>休闲养生网回答:
霉菌形成分枝菌丝的真菌的统称。不是分类学的名词,在分类上属于真菌门的各个亚门。构成霉菌体的基本单位称为菌丝,呈长管状,宽度 2~10微米,可不断自前端生长并分枝。无隔或有隔,具1至多个细胞核。在固体基质上生长时,部分菌丝深入基质吸收养料,称为基质菌丝或营养菌丝;向空中伸展的称气生菌丝,可进一步发育为繁殖菌丝,产生孢子。大量菌丝交织成绒毛状、絮状或网状等,称为菌丝体。菌丝体常呈白色、褐色、灰色,或呈鲜艳的颜色,有的可产生色素使基质着色。霉菌繁殖迅速,常造成食品、用具大量霉腐变质,但许多有益种类已被广泛应用,是人类实践活动中最早利用和认识的一类微生物。
霉菌是丝状真菌的俗称,意即“发霉的真菌”,它们往往能形成分枝繁茂的菌丝体,但又不象蘑菇那样产生大型的子实体。在潮湿温暖的地方,很多物品上长出一些肉眼可见的绒毛状、絮状或蛛网状的菌落,那就是霉菌。
霉菌的菌丝。构成霉菌营养体的基本单位是菌丝。菌丝是一种管状的细丝,把它放在显微镜下观察,很像一根透明胶管,它的直径一般为3-10微米,比细菌和放线菌的细胞约粗几倍到几十倍。菌丝可伸长并产生分枝,许多分枝的菌丝相互交织在一起,就叫菌丝体。
根据菌丝中是否存在隔膜,可把霉菌菌丝分成两种类型:无隔膜菌丝和有隔膜菌丝。无隔膜菌丝中无隔膜,整团菌丝体就是一个单细胞,其中含有多个细胞核。这是低等真菌所具有的菌丝类型。有隔膜菌丝中有隔膜,被隔膜隔开的一段菌丝就是一个细胞,菌丝体由很多个细胞组成,每个细胞内有1个或多个细胞核。在隔膜上有1至多个小孔,使细胞之间的细胞质和营养物质可以相互沟通。这是高等真菌所具有的菌丝类型。休 闲 居 编 辑
为适应不同的环境条件和更有效地摄取营养满足生长发育的需要,许多霉菌的菌丝可以分化成一些特殊的形态和组织,这种特化的形态称为菌丝变态。
吸器。由专性寄生霉菌如锈菌、霜霉菌和白粉菌等产生的菌丝变态,它们是从菌丝上产生出来的旁枝,侵入细胞内分化成根状、指状、球状和佛手状等,用以吸收寄主细胞内的养料。
假根。根霉属霉菌的菌丝与营养基质接触处分化出的根状结构,有固着和吸收养料的功能。
菌网和菌环。某些捕食性霉菌的菌丝变态成环状或网状,用于捕捉其它小生物如线虫、草履虫等。
菌核。大量菌丝集聚成的紧密组织,是一种休眠体,可抵抗不良的环境条件。其外层组织坚硬,颜色较深;内层疏松,大多呈白色。如药用的茯苓、麦角都是菌核。
子实体。是由大量气生菌丝体特化而成,子实体是指在里面或上面可产生孢子的、有一定形状的任何构造。例如有三类能产有性孢子的结构复杂的子实体,分别称为闭囊壳、子囊壳和子囊盘。
霉菌有着极强的繁殖能力,而且繁殖方式也是多种多样的。虽然霉菌菌丝体上任一片段在适宜条件下都能发展成新个体,但在自然界中,霉菌主要依靠产生形形色色的无性或有性孢子进行繁殖。孢子有点像植物的种子,不过数量特别多,特别小。
霉菌的无性孢子直接由生殖菌丝的分化而形成,常见的有节孢子、厚垣孢子、孢囊孢子和分生孢子。
霉菌的孢子具有小、轻、干、多,以及形态色泽各异、休眠期长和抗逆性强等特点,每个个体所产生的孢子数,经常是成千上万的,有时竟达几百亿、几千亿甚至更多。这些特点有助于霉菌在自然界中随处散播和繁殖。对人类的实践来说,孢子的这些特点有利于接种、扩大培养、菌种选育、保藏和鉴定等工作,对人类的不利之处则是易于造成污染、霉变和易于传播动植物的霉菌病害。
由于霉菌的菌丝较粗而长,因而霉菌的菌落较大,有的霉菌的菌丝蔓延,没有局限性,其菌落可扩展到整个培养皿,有的种则有一定的局限性,直径1-2厘米或更小。菌落质地一般比放线菌疏松,外观干燥,不透明,呈现或紧或松的蛛网状、绒毛状或棉絮状;菌落与培养基的连接紧密,不易挑取;菌落正反面的颜色和边缘与中心的颜色常不一致。